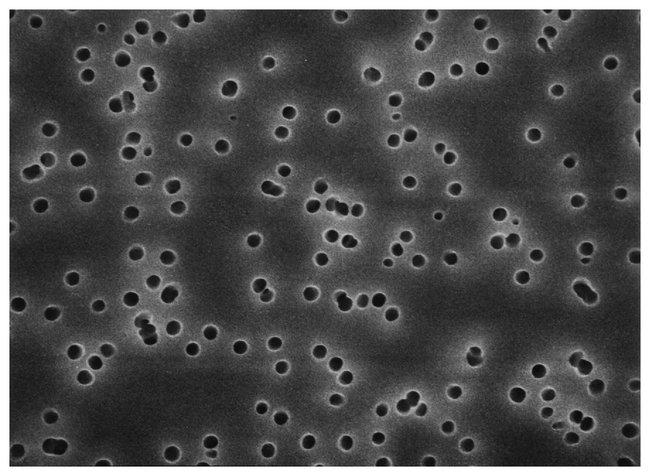

Isopore™ Membrane Filters, 0.4 Μm, Pack Of 100
$ 253.80
|
|
Details:
Use for analyses of airborne contaminants and other particles using optical or electron microscopy. Isopore™ Polycarbonate Membrane Filters have a smooth, glass-like surface for clearer sample observation. Available in a variety of pore sizes/flow rates, diameters and colors.
Additional Information
| SKU | 10141166 |
|---|---|
| UOM | 100/PK |
| UNSPSC | 41104921 |
| Manufacturer Part Number | HTTP02500 |
